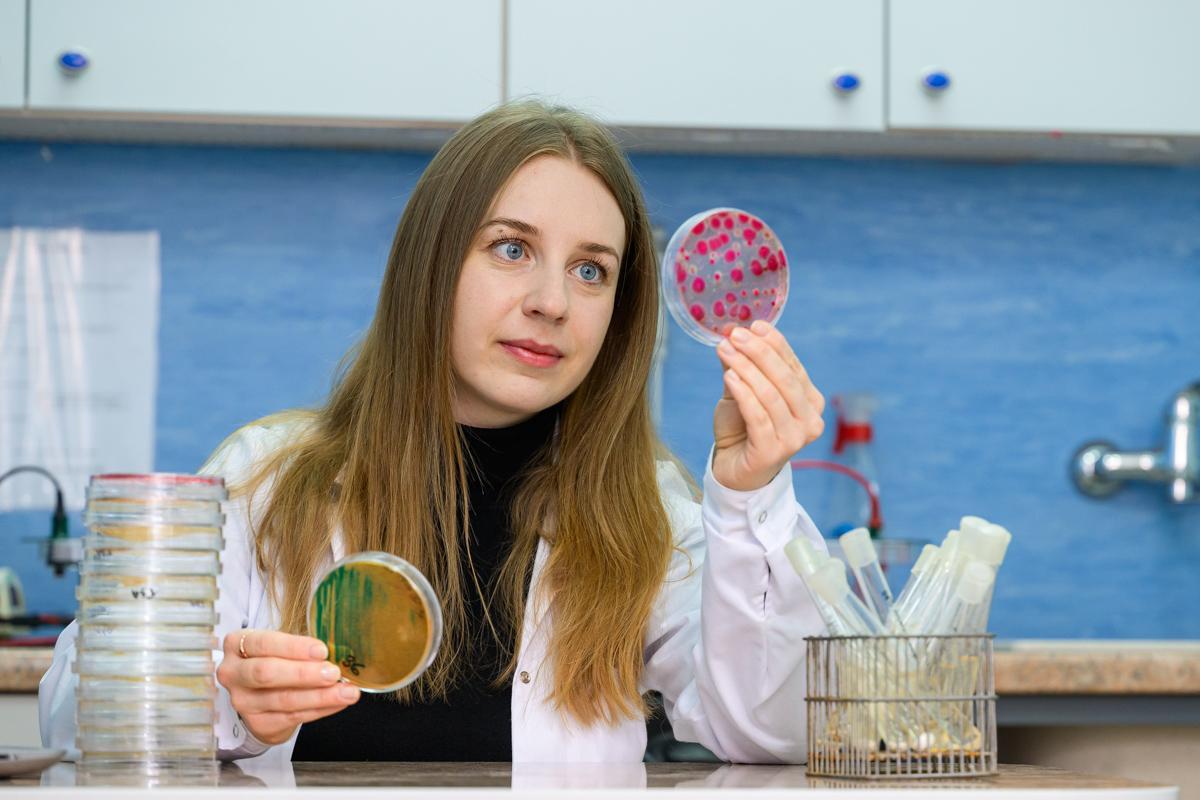

11 Czerwca 2025
Aktualności
Konkurs OPUS 28 skierowany był do naukowców niezależnie od etapu kariery naukowej, którzy planują realizację projektów badawczych, w tym również we współpracy z zagranicznymi zespołami badawczymi.
Mikro- i nanoplastiki PET
Prof. dr hab. Iwona Bogacka z Wydziału Biologii i Biotechnologii będzie realizowała projekt pt. „Mikro- i nanoplastiki PET jako czynniki modulujące komunikację międzykomórkową w nabłonku jajowodów: Rola pęcherzyków zewnątrzkomórkowych". Jest to interdyscyplinarne przedsięwzięcie badawcze we współpracy naukowców z Wydziału Biologii i Biotechnologii, Wydziału Medycyny Weterynaryjnej, a także Instytutu Rozrodu Zwierząt i Badań Żywności Polskiej Akademii Nauk w Olsztynie. Część zadań będzie realizowana we współpracy międzynarodowej z naukowcami z Uniwersytetu Południowej Danii w Odense oraz Czeskiej Akademii Nauk w Liběchovie.
Fot. Janusz Pająk
– Koncentruje się na badaniach nad wpływem cząsteczek PET na funkcjonowanie nabłonka jajowodów – struktury odgrywającej kluczową rolę w procesach rozrodczych samic ssaków. Głównym obiektem badań będą pęcherzyki zewnątrzkomórkowe (ang. extracellular vesicles, EVs), czyli mikroskopijne struktury uczestniczące w transporcie biologicznie aktywnych cząsteczek takich jak białka, lipidy i mikroRNA, pomiędzy komórkami. Wykorzystując unikalny, trójwymiarowy system hodowli komórek nabłonkowych jajowodu świni, badacze stworzą sferoidy komórkowe, które będą utrzymywane w warunkach mikrograwitacji oraz eksponowane na różne stężenia mikro- i nanoplastiku – wyjaśnia prof. Iwona Bogacka.
Projekt zespołu prof. Bogackiej wpisuje się w globalny nurt badań nad wpływem zanieczyszczeń środowiskowych na zdrowie organizmów. Zgłębienie molekularnych mechanizmów oddziaływania mikro- i nanoplastików PET na komórki nabłonka jajowodu może istotnie poszerzyć wiedzę w zakresie biologii rozrodu. Równocześnie, uzyskane wyniki mogą odegrać istotną rolę w kształtowaniu świadomości społecznej w kontekście zagrożeń związanych z obecnością tworzyw sztucznych w środowisku.
Zrównoważona remediacja gleb
Dr hab. Mariusz Gusiatin, prof. UWM z Wydziału Geoinżynierii UWM również znalazł się wśród laureatów konkursów i będzie realizował projekt pt.: „Biowęgiel z ko-pirolizy osadów ściekowych i jego wpływ na zrównoważoną remediację gleb, sekwestrację węgla oraz ograniczanie emisji gazów cieplarnianych".
Fot. archiwum prywatne
– Celem naszego projektu jest ocena, czy tzw. ulepszony biowęgiel wytworzony z osadów ściekowych w połączeniu z innymi odpadami, może pomóc oczyścić glebę z metali ciężkich, poprawić jej jakość, warunki dla roślin, zatrzymać węgiel w glebie i ograniczyć emisję gazów cieplarnianych, takich jak dwutlenek węgla czy metan – wyjaśnia prof. Mariusz Gusiatin i dodaje:
– Jak wiadomo, zanieczyszczenie środowiska jest obecnie jednym z największych wyzwań. Istnieje potrzeba oczyszczania gleb, jednak te metody muszą spełniać różnego rodzaju standardy – chodzi o to, aby nie szkodziły środowisku. I na tym właśnie polega zrównoważona remediacja. Jako naukowcy poszukujemy różnych innowacyjnych i ekologicznych rozwiązań. Stąd pomysł wykorzystania biowęgla, do którego wyprodukowania wykorzystamy proces ko-pirolizy odpadów, czyli przetworzenia komunalnych osadów ściekowych, odpadów rolniczych i leśnych w wysokiej temperaturze (300-700 st. C) bez dostępu tlenu.
Projekt został podzielony na pięć kluczowych etapów: wytworzenie biowęgla przy użyciu różnych proporcji odpadów oraz temperatur pirolizy, badania wstępne w laboratorium, weryfikacja w testach polowych z udziałem roślin i mikroorganizmów glebowych, badanie procesu starzenia się biowęgla w zależności od pory roku, monitorowanie emisji gazów cieplarnianych z gleb wzbogaconych biowęglem. Niektóre etapy badań będą realizowane z University of Chemistry and Technology w Pradze, w ramach współpracy międzynarodowej.
Mikrozanieczyszczenia a oporność na antybiotyki
Grant OPUS 28 otrzymała również dr inż. Małgorzata Czatzkowska z Wydziału Geoinżynierii UWM. Naukowczyni będzie realizowała projekt badawczy pt. „Poznanie mechanizmów koselekcji oporności na antybiotyki i metale ciężkie podczas fermentacji metanowej osadów ściekowych w oparciu o sekwencjonowanie metagenomu w technologii nanoporowej”. Dr inż. Czatzkowska jest także laureatką konkursu w programie stypendialnym START 2025 Fundacji na rzecz Nauki Polskiej.
Fot. Janusz Pająk
– Fermentacja metanowa to proces wykorzystywany do stabilizacji różnego rodzaju odpadów, m.in. osadów ściekowych, które są produktem ubocznym procesu oczyszczania ścieków. W tych odpadach kryją się różnego rodzaju zanieczyszczenia, m.in. antybiotyki i metale ciężkie. Będę sprawdzała, w jaki sposób obecność tych mikrozanieczyszczeń, występujących zarówno indywidualnie jak i w różnych kombinacjach, wpływa na szerzenie wśród bakterii genów warunkujących oporność na antybiotyki, a także oporność na metale ciężkie. Skupię się na zjawisku koselekcji tych genów – mówi dr inż. Małgorzata Czatzkowska i dodaje, że nie tylko obecność antybiotyków w środowisku sprawia, że rozprzestrzenia się zjawisko antybiotykooporności. Przyczyniają się do tego także metale ciężkie.
Badania będą kontynuacją wcześniejszych działań związanych z problemem oporności bakterii na leki w różnych środowiskach.
– W badaniach wykorzystam molekularną metodę sekwencjonowania metagenomowego w technologii nanoporowej, co umożliwia otrzymanie długich odczytów DNA. Dzięki temu będę mogła poznać konkretną lokalizację genów kodujących oporność na antybiotyki i metale ciężkie, czyli ich kontekst genetyczny. Możliwe jest ich wspólne przenoszenie za pośrednictwem mobilnych elementów genetycznych, np. plazmidów – dodaje badaczka z UWM.
Projekt otrzymał dofinansowanie w wysokości ponad miliona złotych. Realizowany będzie przez trzy lata.
Biowęgiel a mikrobiota jelitowa i zrównoważony rozwój czarnej muchy
Projekt pt. „Czy biowęgiel wpływa na mikrobiotę jelitową i zrównoważony rozwój czarnej muchy?" realizują dr hab. Michał Krzyżaniak, prof. UWM i dr inż. Sebastian Przemieniecki z Wydziału Rolnictwa i Leśnictwa UWM, a kierownikiem jest dr inż. Piotr Bulak z Instytutu Agrofizyki PAN.
Fot. archiwum prywatne
– Celem projektu jest pogłębienie wiedzy na temat możliwości zastosowania dodatku biowęgla do pasz dla larw czarnej muchy, owada komercyjnie hodowanego na całym świecie w celu produkcji białka i tłuszczu, wykorzystywanych w kompozycjach paszowych dla innych zwierząt. Natomiast stosowanie biowęgla w diecie „klasycznych" zwierząt gospodarskich jest znane od wieków i dobrze uzasadnione korzystnym, wielokierunkowym wpływem. Jego korzystne działanie na zwierzęta wiąże się z adsorpcją różnego rodzaju związków toksycznych, antyżywieniowych. Biowęgiel wiąże także na swojej powierzchni bakterie chorobotwórcze. U zwierząt hodowanych z dodatkiem biowęgla obserwowano wzrost masy ciała i zmniejszenie współczynnika wykorzystania paszy, co oznacza, że większy przyrost biomasy następował przy lepszym wykorzystaniu karmy. Wreszcie obserwowano również redukcję emisji metanu i dwutlenku węgla – tłumaczy prof. Michał Krzyżaniak.
Dotychczas nie przeprowadzono badań nad wykorzystaniem biowęgla w żywieniu owadów gospodarskich. Brakuje także badań poświęconych wpływowi biowęgla na zmiany emisji gazów cieplarnianych z takich hodowli. Wyniki podjętych w grancie prac, mogą mieć znaczenie dla hodowców owadów gospodarskich. Badania dotyczące zmian mikrobiomu owadów pod wpływem biowęgla mogą z kolei odpowiedzieć na wiele kluczowych pytań dotyczących powiązania fizjologii czarnej muchy z konkretnymi rodzajami bakterii i grzybów, a także mieć wpływ na określenie bezpieczeństwa stosowania owadów jako karmy dla innych zwierząt, w związku z ograniczeniem możliwości występowania bakterii patogennych.
mw, aw
Autorka grafiki: Julka Gumowska, studentka Wydziału Sztuki


